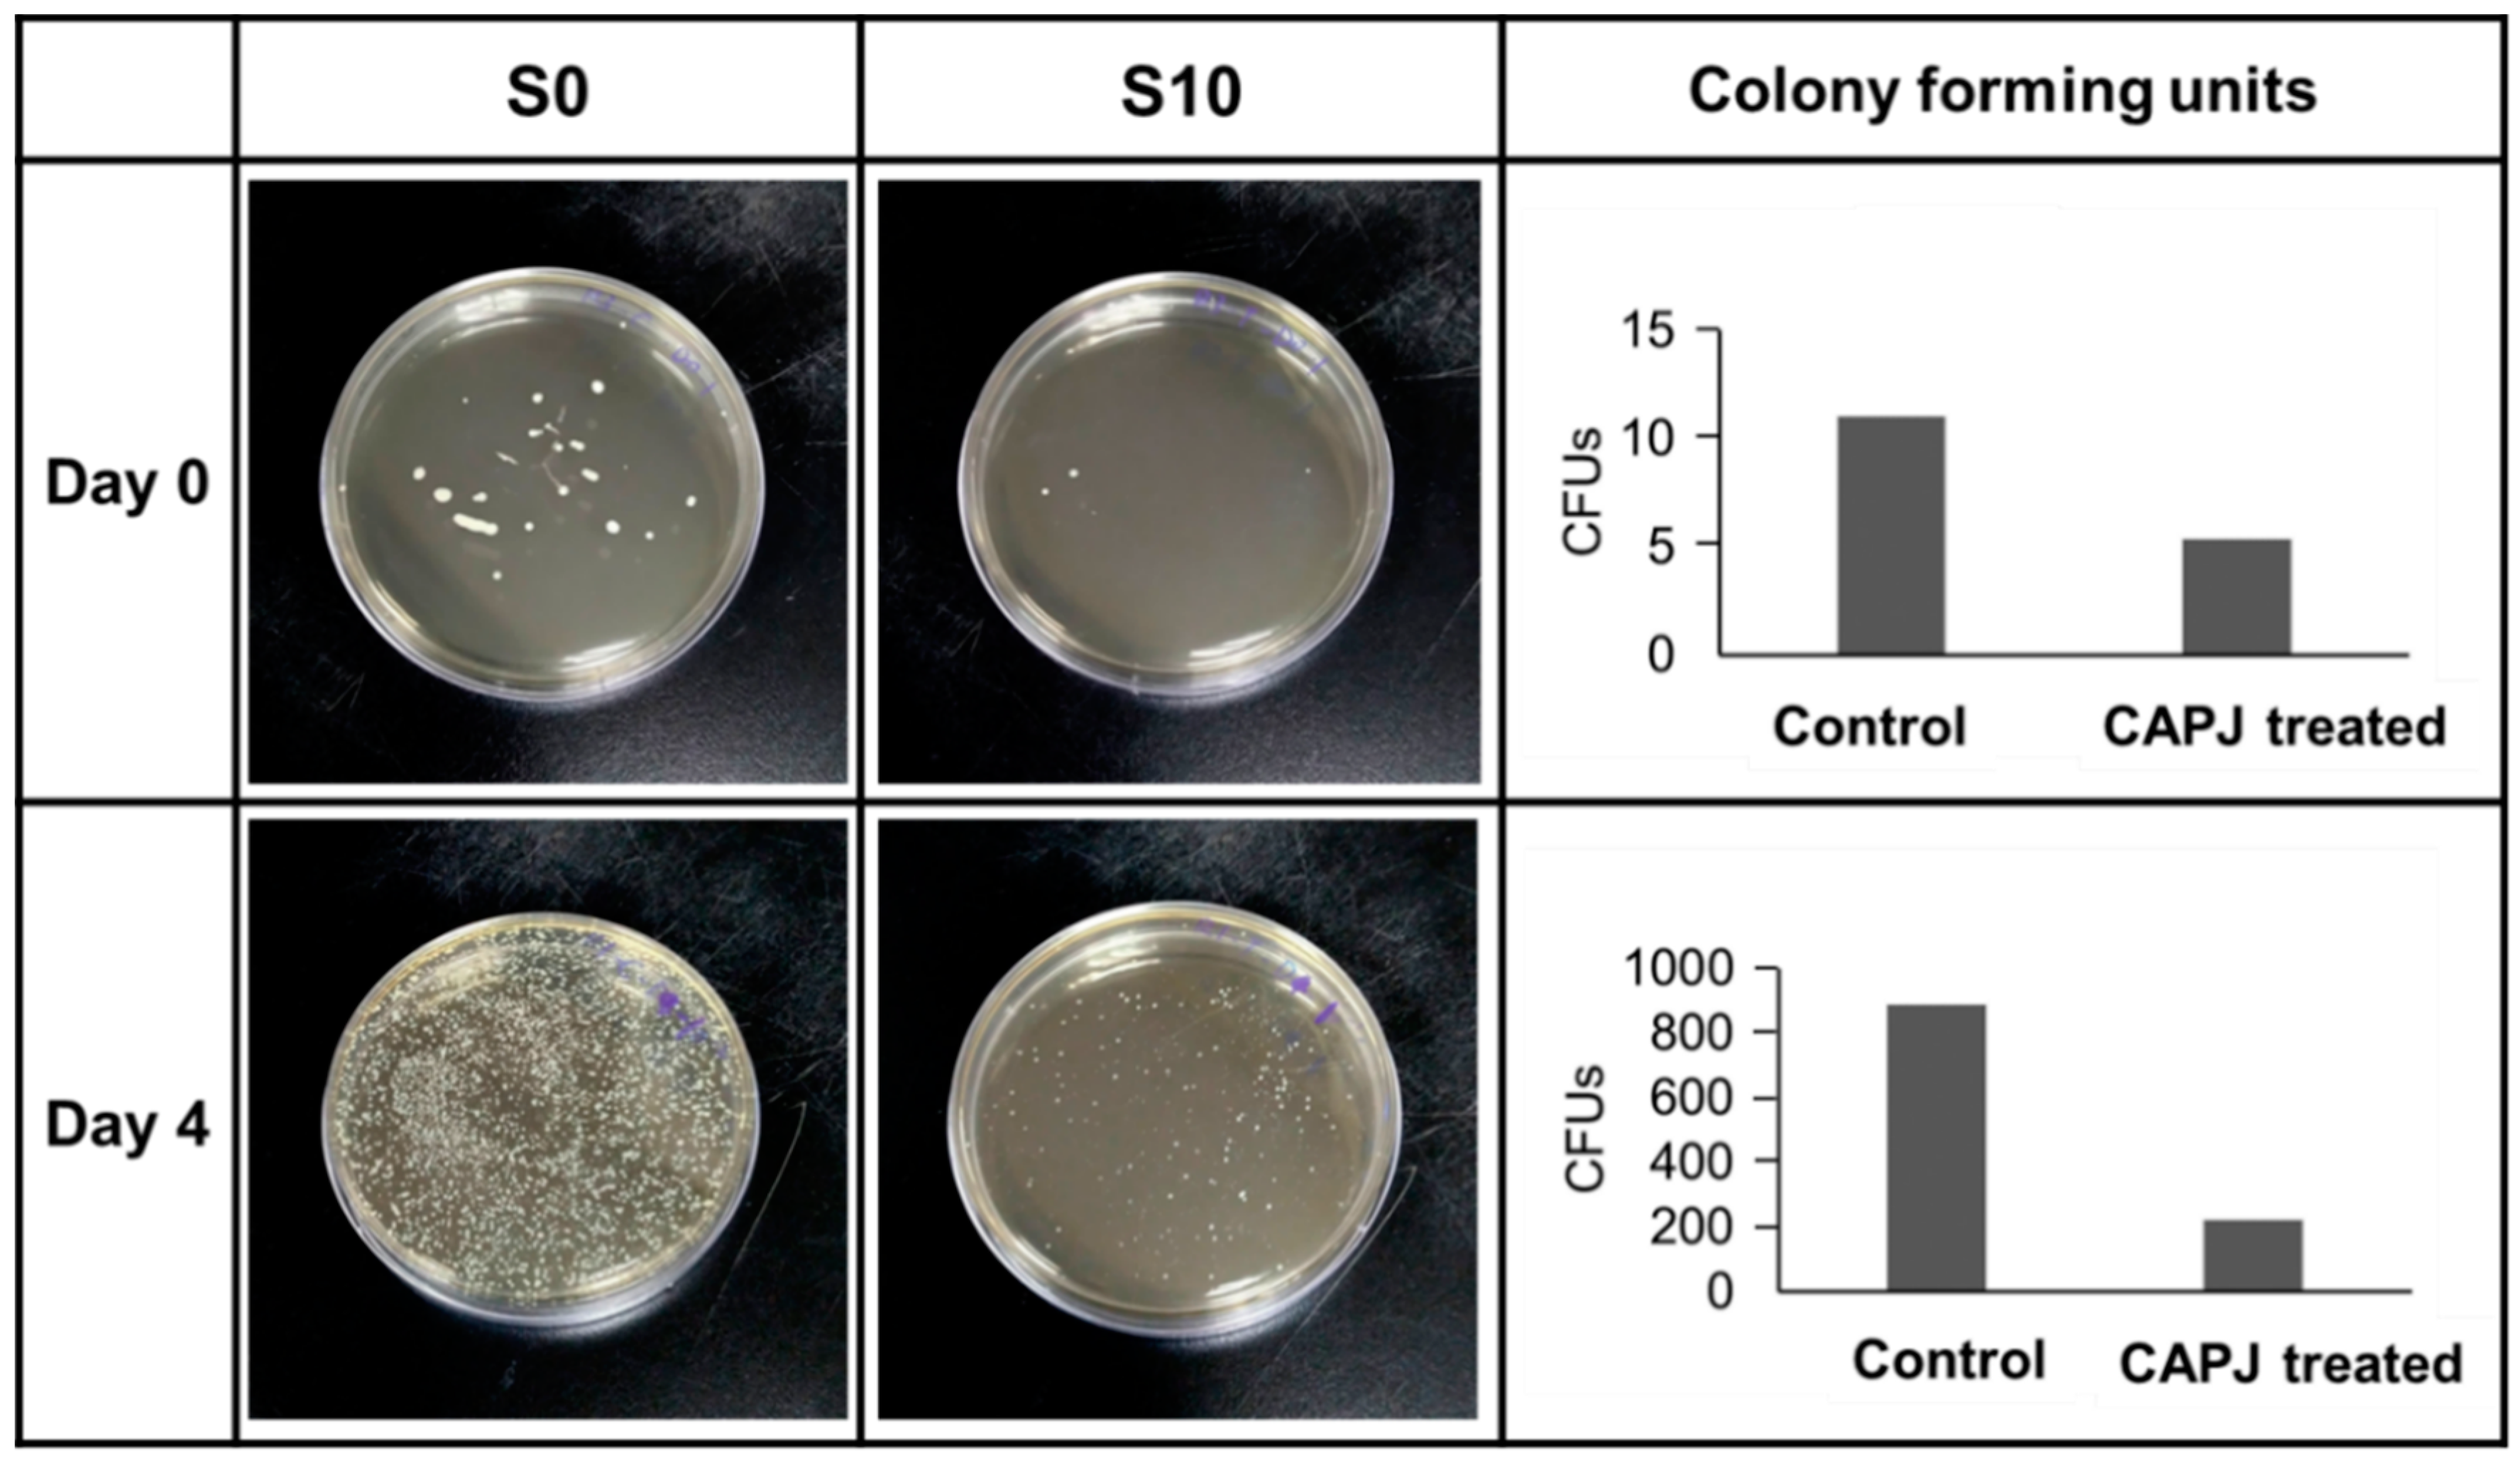
Jcm 08 01930 g009

Parameters Affecting the Antimicrobial Properties of Cold Atmospheric Plasma Jet
Abstract
1. Introduction
2. Experimental Section
2.1. Plasma Experimental Setup
2.2. Bacterial Strain and Culture
2.3. In Vitro Growth Inhibition Assay
2.4. Taguchi Method
2.5. Bacterial Viability Assay
2.6. DNA Damage Assay
2.7. Field Emission Scanning Electron Microscope Analysis
2.8. In Vivo Evaluation
2.9. Statistical Analysis
3. Results
3.1. Plasma Characterization
3.2. CAPJ Possess Bactericidal Activity
3.3. Analysis of the Bactericidal Activity by Using Taguchi Method
3.4. Validation of Bactericidal Activity Conferred by CAPJ Treated under S10
3.5. CAPJ Treatment Induced DNA Double-Strand Breaks (DSB) and Disruption of Cell Wall Integrity
3.6. In Vivo Evaluation
4. Discussion
5. Conclusions
Author Contributions
Funding
Conflicts of Interest
References
- Weltmann, K.D.; Von Woedtke, T. Plasma medicine-current state of research and medical application. Plasma Phys. Control. Fusion 2016, 59, 014031. [Google Scholar] [CrossRef]
- Kong, M.G.; Kroesen, G.; Morfill, G.; Nosenko, T.; Shimizu, T.; van Dijk, J.; Zimmermann, J.L. Plasma medicine: An introductory review. New J. Phys. 2009, 11, 115012. [Google Scholar]
- Laroussi, M. Low temperature plasma-based sterilization: Overview and state-of-the-art. Plasma Process Polym. 2005, 2, 391–400. [Google Scholar] [CrossRef]
- Ehlbeck, J.; Schnabel, U.; Polak, M.; Winter, J.; Von Woedtke, T.; Brandenburg, R.; Von dem Hagen, T.; Weltmann, K.D. Low temperature atmospheric pressure plasma sources for microbial decontamination. J. Phys. D Appl. Phys. 2010, 44, 013002. [Google Scholar] [CrossRef]
- Von Woedtke, T.; Reuter, S.; Masur, K.; Weltmann, K.D. Plasmas for medicine. Phys. Rep. 2013, 530, 291–320. [Google Scholar] [CrossRef]
- Penkov, O.V.; Khadem, M.; Lim, W.S.; Kim, D.E. A review of recent applications of atmospheric pressure plasma jets for materials processing. J. Coat. Technol. Res. 2015, 12, 225–235. [Google Scholar] [CrossRef]
- Bruggeman, P.J.; Sadeghi, N.; Schram, D.C.; Linss, V. Gas temperature determination from rotational lines in non-equilibrium plasmas: A review. Plasma Sources Sci. Technol. 2014, 23, 023001. [Google Scholar] [CrossRef]
- Uchida, G.; Mino, Y.; Suzuki, T.; Ikeda, J.I.; Suzuki, T.; Takenaka, K.; Setsuhara, Y. Decomposition and oxidation of methionine and tryptophan following irradiation with a nonequilibrium plasma jet and applications for killing cancer cells. Sci. Rep. 2019, 9, 6625. [Google Scholar] [CrossRef]
- Vandamme, M.; Robert, E.; Lerondel, S.; Sarron, V.; Ries, D.; Dozias, S.; Sobilo, J.; Gosset, D.; Kieda, C.; Legrain, B.; et al. ROS implication in a new antitumor strategy based on non-thermal plasma. Int. J. Cancer 2012, 130, 2185–2194. [Google Scholar] [CrossRef]
- Homma, T.; Furuta, M.; Takemura, Y. Inactivation of Escherichia coli Using the Atmospheric Pressure Plasma Jet of Ar Gas. Jpn. J. Appl. Phys. 2013, 52, 036201. [Google Scholar] [CrossRef]
- Klämpfl, T.G.; Isbary, G.; Shimizu, T.; Li, Y.F.; Zimmermann, J.L.; Stolz, W.; Schlegel, J.; Morfill, G.E.; Schmidt, H.U. Cold atmospheric air plasma sterilization against spores and other microorganisms of clinical interest. Appl. Environ. Microbiol. 2012, 78, 5077–5082. [Google Scholar] [CrossRef] [PubMed]
- Choi, Y.; Lee, S.; Lee, H.; Lee, S.; Kim, S.; Lee, J.; Ha, J.; Oh, H.; Lee, Y.; Kim, Y.; et al. Rapid Detection of Escherichia coli in Fresh Foods Using a Combination of Enrichment and PCR Analysis. Korean J. Food Sci. Anim. Resour. 2018, 38, 829. [Google Scholar] [PubMed]
- Bryce, A.; Hay, A.D.; Lane, I.F.; Thornton, H.V.; Wootton, M.; Costelloe, C. Global prevalence of antibiotic resistance in paediatric urinary tract infections caused by Escherichia coli and association with routine use of antibiotics in primary care: Systematic review and meta-analysis. Bmj 2016, 352, i939. [Google Scholar] [CrossRef]
- Abo Basha, J.; Kiel, M.; Görlich, D.; Schütte-Nütgen, K.; Witten, A.; Pavenstädt, H.; Kahl, B.C.; Dobrindt, U.; Reuter, S. Phenotypic and Genotypic Characterization of Escherichia coli Causing Urinary Tract Infections in Kidney-Transplanted Patients. J. Clin. Med. 2019, 8, 988. [Google Scholar] [CrossRef] [PubMed]
- Devaney, J.; Horie, S.; Masterson, C.; Elliman, E.; Barry, F.; O’Brien, T.; Curley, G.; Toole, D.; Laffey, J. Human mesenchymal stromal cells decrease the severity of acute lung injury induced by E. coli in the rat. Thorax 2015, 70, 625–635. [Google Scholar] [CrossRef]
- Chen, H.C.; Lin, W.L.; Lin, C.C.; Hsieh, W.H.; Hsieh, C.H.; Wu, M.H.; Wu, J.Y.; Lee, C.C. Outcome of inadequate empirical antibiotic therapy in emergency department patients with community-onset bloodstream infections. J. Antimicrob. Chemother. 2013, 68, 947–953. [Google Scholar] [CrossRef] [PubMed]
- Vila, J.; Sáez-López, E.; Johnson, J.R.; Römling, U.; Dobrindt, U.; Cantón, R.; Giske, C.G.; Naas, T.; Carattoli, A.; Martínez-Medina, M.; et al. Escherichia coli: An old friend with new tidings. FEMS Microbiol. Rev. 2016, 40, 437–463. [Google Scholar] [CrossRef]
- Peralta, G.; Sanchez, M.B.; Garrido, J.C.; De Benito, I.; Cano, M.E.; Martínez-Martínez, L.; Roiz, M.P. Impact of antibiotic resistance and of adequate empirical antibiotic treatment in the prognosis of patients with Escherichia coli bacteraemia. J. Antimicrob. Chemother. 2007, 60, 855–863. [Google Scholar] [CrossRef]
- Wang, J.L.; Lee, C.C.; Lee, C.H.; Lee, N.Y.; Hsieh, C.C.; Hung, Y.P.; Tang, H.J.; Ko, W.C. Clinical Impact of Sequence Type 131 in Adults with Community-Onset Monomicrobial Escherichia Coli Bacteremia. J. Clin. Med. 2018, 7, 508. [Google Scholar] [CrossRef]
- Ross, P.J. Taguchi Techniques for Quality Engineering; McGraw-Hill International Book Company: New York, NY, USA, 1996. [Google Scholar]
- Dhawane, S.H.; Kumar, T.; Halder, G. Biodiesel synthesis from Hevea brasiliensis oil employing carbon supported heterogeneous catalyst: Optimization by Taguchi method. Renew. Energy 2016, 89, 506–514. [Google Scholar] [CrossRef]
- Sivasakthivel, T.; Murugesan, K.; Thomas, H.R. Optimization of operating parameters of ground source heat pump system for space heating and cooling by Taguchi method and utility concept. Appl. Energy 2014, 116, 76–85. [Google Scholar] [CrossRef]
- Chang, C.T.; Yang, Y.C.; Lee, J.W.; Lou, B.S. The influence of deposition parameters on the structure and properties of aluminum nitride coatings deposited by high power impulse magnetron sputtering. Thin Solid Films 2014, 572, 161–168. [Google Scholar] [CrossRef]
- Bolouki, N.; Hsieh, J.H.; Li, C.; Yang, Y.Z. Emission Spectroscopic Characterization of a Helium Atmospheric Pressure Plasma Jet with Various Mixtures of Argon Gas in the Presence and the Absence of De-Ionized Water as a Target. Plasma 2019, 2, 20. [Google Scholar] [CrossRef]
- Mai-Prochnow, A.; Murphy, A.B.; McLean, K.M.; Kong, M.G.; Ostrikov, K.K. Atmospheric pressure plasmas: Infection control and bacterial responses. Inter. J. Antimicrob. Agents 2014, 43, 508–517. [Google Scholar] [CrossRef]
- Kochure, P.G.; Nandurkar, K.N. Application of taguchi methodology in selection of process parameters for induction hardening of EN8 D Steel. IJMER 2012, 2, 3736–3742. [Google Scholar]
- Boulos, L.; Prévost, M.; Barbeau, B.; Coallier, J.; Desjardins, R. LIVE/DEAD® BacLight™: Application of a new rapid staining method for direct enumeration of viable and total bacteria in drinking water. J. Microbiol. Methods 1999, 37, 77–86. [Google Scholar] [CrossRef]
- Dunn, L.; Prosser, H.C.; Tan, J.T.; Vanags, L.Z.; Ng, M.K.; Bursill, C.A. Murine model of wound healing. JoVE 2013, 75, e50265. [Google Scholar] [CrossRef]
- Kubinova, S.; Zaviskova, K.; Uherkova, L.; Zablotskii, V.; Churpita, O.; Lunov, O.; Dejneka, A. Non-thermal air plasma promotes the healing of acute skin wounds in rats. Sci. Rep. 2017, 7, 45183. [Google Scholar] [CrossRef]
- Wende, K.; Williams, P.; Dalluge, J.; Van Gaens, W.; Aboubakr, H.; Bischof, J.; Von Woedtke, T.; Goyal, S.M.; Weltmann, K.D.; Bogaerts, A.; et al. Identification of the biologically active liquid chemistry induced by a nonthermal atmospheric pressure plasma jet. Biointerphases 2015, 10, 029518. [Google Scholar] [CrossRef]
- Ahn, H.J.; Kim, K.I.; Hoan, N.N.; Kim, C.H.; Moon, E.; Choi, K.S.; Yang, S.S.; Lee, J.S. Targeting cancer cells with reactive oxygen and nitrogen species generated by atmospheric-pressure air plasma. PLoS ONE 2014, 9, e86173. [Google Scholar] [CrossRef]
- World Health Organization. Prioritization of Pathogens to Guide Discovery, Research and Development of New Antibiotics for Drug-Resistant Bacterial Infections, Including Tuberculosis; World Health Organization: Geneva, Switzerland, 2017. [Google Scholar]
- Unal, R.; Dean, E.B. Taguchi approach to design optimization for quality and cost: An overview. In Proceedings of the 13th Annual Conference of the International Society of Parametric Analysts, New Orleans, LA, USA, 21–24 May 1991. [Google Scholar]
- Graves, D.B. The emerging role of reactive oxygen and nitrogen species in redox biology and some implications for plasma applications to medicine and biology. J. Phys. D Appl. Phys. 2012, 45, 42. [Google Scholar] [CrossRef]
- Moisan, M.; Barbeau, J.; Crevier, M.C.; Pelletier, J.; Philip, N.; Saoudi, B. Plasma sterilization. Methods and Mechanisms. Pure Appl. Chem. 2002, 74, 349–358. [Google Scholar] [CrossRef]
- Boudam, M.K.; Moisan, M.; Saoudi, B.; Popovici, C.; Gherardi, N.; Massines, F. Bacterial spore inactivation by atmospheric-pressure plasmas in the presence or absence of UV photons as obtained with the same gas mixture. J. Phys. D Appl. Phys. 2006, 39, 3494. [Google Scholar] [CrossRef]
- Brun, P.; Bernabè, G.; Marchiori, C.; Scarpa, M.; Zuin, M.; Cavazzana, R.; Zaniol, B.; Martines, E. Antibacterial efficacy and mechanisms of action of low power atmospheric pressure cold plasma: Membrane permeability, biofilm penetration and antimicrobial sensitization. J. Appl. Microbiol. 2018, 125, 398–408. [Google Scholar] [CrossRef]
- Vatansever, F.; de Melo, W.C.; Avci, P.; Vecchio, D.; Sadasivam, M.; Gupta, A.; Chandran, R.; Karimi, M.; Parizotto, N.A.; Yin, R.; et al. Antimicrobial strategies centered around reactive oxygen species--bactericidal antibiotics, photodynamic therapy, and beyond. FEMS Microbiol. Rev. 2013, 37, 955–958. [Google Scholar] [CrossRef]
- Mylonas, C.; Kouretas, D. Lipid peroxidation and tissue damage. In Vivo (Athens Greece) 1999, 13, 295–309. [Google Scholar]
- Joshi, S.G.; Cooper, M.; Yost, A.; Paff, M.; Ercan, U.K.; Fridman, G.; Friedman, G.; Fridman, A.; Brooks, A.D. Nonthermal dielectric-barrier discharge plasma-induced inactivation involves oxidative DNA damage and membrane lipid peroxidation in Escherichia coli. Antimicrob. Agents Chemother. 2011, 55, 1053–1062. [Google Scholar] [CrossRef]
- Hosseinzadeh Colagar, A.; Memariani, H.; Sohbatzadeh, F.; Valinataj Omran, A. Nonthermal atmospheric argon plasma jet effects on Escherichia coli biomacromolecules. Appl. Biochem. Biotechnol. 2013, 171, 1617–1629. [Google Scholar] [CrossRef]
- Yusupov, M.; Neyts, E.C.; Khalilov, U.; Snoeckx, R.; Van Duin, A.C.T.; Bogaerts, A. Atomic-scale simulations of reactive oxygen plasma species interacting with bacterial cell walls. New J. Phys. 2012, 14, 093043. [Google Scholar] [CrossRef]
- Brandenburg, R.; Ehlbeck, J.; Stieber, M.; von Woedtke, T.; Zeymer, J.; Schlüter, O.; Weltmann, K.D. Antimicrobial treatment of heat sensitive materials by means of atmospheric pressure Rf-driven plasma jet. Contrib. Plasma Phys. 2007, 47, 72–79. [Google Scholar] [CrossRef]
- Gaunt, L.F.; Beggs, C.B.; Georghiou, G.E. Bactericidal action of the reactive species produced by gas-discharge nonthermal plasma at atmospheric pressure: A review. IEEE Trans. Plasma Sci. 2006, 34, 1257–1269. [Google Scholar] [CrossRef]
- Shen, J.; Cheng, C.; Fang, S.; Xie, H.; Lan, Y.; Ni, G.; Meng, Y.; Luo, J.; Wang, X. Sterilization of Bacillus subtilis spores using an atmospheric plasma jet with argon and oxygen mixture gas. Appl. Phys. Express 2012, 5, 036201. [Google Scholar] [CrossRef]
- Kohanski, M.A.; Dwyer, D.J.; Hayete, B.; Lawrence, C.A.; Collins, J.J. A common mechanism of cellular death induced by bactericidal antibiotics. Cell 2007, 130, 797–810. [Google Scholar] [CrossRef] [PubMed]
- Kang, S.K.; Choi, M.Y.; Koo, I.G.; Kim, P.Y.; Kim, Y.; Kim, G.J.; Mohamed, A.A.H.; Collins, G.J.; Lee, J.K. Reactive hydroxyl radical-driven oral bacterial inactivation by radio frequency atmospheric plasma. Appl. Phys. Lett. 2011, 98, 143702. [Google Scholar] [CrossRef]
- Yang, H.; Wang, W.S.; Tan, Y.; Zhang, D.J.; Wu, J.J.; Lei, X. Investigation and analysis of the characteristics and drug sensitivity of bacteria in skin ulcer infections. Chin. J. Traumatol. 2017, 20, 194–197. [Google Scholar] [CrossRef] [PubMed]
- Isbary, G.; Morfill, G.; Schmidt, H.U.; Georgi, M.; Ramrath, K.; Heinlin, J.; Karrer, S.; Landthaler, M.; Shimizu, T.; Steffes, B.; et al. A first prospective randomized controlled trial to decrease bacterial load using cold atmospheric argon plasma on chronic wounds in patients. Br. J. Dermatol. 2010, 163, 78–82. [Google Scholar] [CrossRef]
- Daeschlein, G.; Napp, M.; Lutze, S.; Arnold, A.; von Podewils, S.; Guembel, D.; Jünger, M. Skin and wound decontamination of multidrug-resistant bacteria by cold atmospheric plasma coagulation. JDDG 2015, 13, 143–149. [Google Scholar] [CrossRef]

| Symbol | Process Parameter | Level 1 | Level 2 | Level 3 |
|---|---|---|---|---|
| A | Application voltage (kV) | 6.5 | 7.5 | 8.5 |
| B | CAPJ-sample distance (mm) | 10 | 20 | 30 |
| C | Ar gas flow rate (sccm) | 0 | 200 | 500 |
| D | CAPJ treatment time (s) | 60 | 180 | 300 |
| Sample # | Control Factors | |||
|---|---|---|---|---|
| A | B | C | D | |
| S1 | 1 | 1 | 1 | 1 |
| S2 | 1 | 2 | 2 | 2 |
| S3 | 1 | 3 | 3 | 3 |
| S4 | 2 | 1 | 2 | 3 |
| S5 | 2 | 2 | 3 | 1 |
| S6 | 2 | 3 | 1 | 2 |
| S7 | 3 | 1 | 3 | 2 |
| S8 | 3 | 2 | 1 | 3 |
| S9 | 3 | 3 | 2 | 1 |
| Sample Designation | S1 | S2 | S3 | S4 | S5 | S6 | S7 | S8 | S9 | |
|---|---|---|---|---|---|---|---|---|---|---|
| CAPJ conditions | A (kV) | 6.5 | 6.5 | 6.5 | 7.5 | 7.5 | 7.5 | 8.5 | 8.5 | 8.5 |
| B (mm) | 10 | 20 | 30 | 10 | 20 | 30 | 10 | 20 | 30 | |
| C (sccm) | 0 | 200 | 500 | 200 | 500 | 0 | 500 | 0 | 200 | |
| D (s) | 60 | 180 | 300 | 300 | 60 | 180 | 180 | 300 | 60 | |
| Sample Designation. | S1 | S2 | S3 | S4 | S5 | S6 | S7 | S8 | S9 |
|---|---|---|---|---|---|---|---|---|---|
| Bactericidal activity (%) | 45.7 | 31.3 | 90.6 | 92.8 | 53.2 | 37.7 | 85.9 | 100.0 | 22.6 |
| Source of Variance | Degree of Freedom | Sum of Square | Variance | Contribution (%) | |
|---|---|---|---|---|---|
| A, | Application voltage (kV) | 2 | 0.68 | 0.01 | 0.2 |
| B, | CAPJ-sample distance (mm) | 2 | 34.04 | 0.69 | 11.2 |
| C, | Ar gas flow rate (sccm) | 2 | 36.15 | 0.74 | 12.1 |
| D, | CAPJ treatment time (s) | 2 | 111.04 | 4.70 | 76.5 |
| Total | 8 | 181.91 | 6.15 | 100.0 | |
© 2019 by the authors. Licensee MDPI, Basel, Switzerland. This article is an open access article distributed under the terms and conditions of the Creative Commons Attribution (CC BY) license (http://creativecommons.org/licenses/by/4.0/).
Share and Cite
Lou, B.-S.; Lai, C.-H.; Chu, T.-P.; Hsieh, J.-H.; Chen, C.-M.; Su, Y.-M.; Hou, C.-W.; Chou, P.-Y.; Lee, J.-W. Parameters Affecting the Antimicrobial Properties of Cold Atmospheric Plasma Jet. J. Clin. Med. 2019, 8, 1930. https://doi.org/10.3390/jcm8111930
Lou B-S, Lai C-H, Chu T-P, Hsieh J-H, Chen C-M, Su Y-M, Hou C-W, Chou P-Y, Lee J-W. Parameters Affecting the Antimicrobial Properties of Cold Atmospheric Plasma Jet. Journal of Clinical Medicine. 2019; 8(11):1930. https://doi.org/10.3390/jcm8111930
Chicago/Turabian StyleLou, Bih-Show, Chih-Ho Lai, Teng-Ping Chu, Jang-Hsing Hsieh, Chun-Ming Chen, Yu-Ming Su, Chun-Wei Hou, Pang-Yun Chou, and Jyh-Wei Lee. 2019. "Parameters Affecting the Antimicrobial Properties of Cold Atmospheric Plasma Jet" Journal of Clinical Medicine 8, no. 11: 1930. https://doi.org/10.3390/jcm8111930
APA StyleLou, B.-S., Lai, C.-H., Chu, T.-P., Hsieh, J.-H., Chen, C.-M., Su, Y.-M., Hou, C.-W., Chou, P.-Y., & Lee, J.-W. (2019). Parameters Affecting the Antimicrobial Properties of Cold Atmospheric Plasma Jet. Journal of Clinical Medicine, 8(11), 1930. https://doi.org/10.3390/jcm8111930





_周(Chou).jpg)

